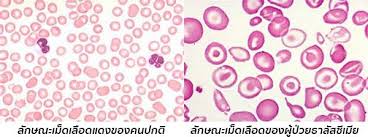
ธาลาสซีเมีย

โฟลีวิต (หนัก 40 กรัม)
250฿
- โฟลีวิต 100 เม็ด
- เพื่อสร้างเม็ดเลือดแดง สูญเสียการเสียเลือด
หมวดหมู่: วิตามินเกลือแร่
ป้ายกำกับ: ผู้หญิง
โฟลีวิต สร้างเม็ดเลือดแดง 100 เม็ด
– 1 ขวดบรรจุ 100 เม็ด
– ผลิตภัณฑ์ของบริษัท สยามฟาร์มาซูติคอล จำกัด
สรรพคุณ
1. เพื่อสร้างเม็ดเลือดแดง
2. เสริมสร้างกระบวนการเจริญเติบโตของร่างกาย
3. ป้องกันและรักษาอาการเจ็บป่วยจากการขาดกรดโฟลิค
4. รักษาอาการโลหิตจางในผู้ป่วยธาลาสซีเมีย
วิธีรับประทาน : วันละ 1 เม็ด และสามารถรับประทานได้ถึงวันละ 3 เม็ด
– ส่วนประกอบสำคัญ : ใน 1 เม็ด มี Folic acid 5 มิลลิกรัม
- Folic Acid (กรดโฟลิค) เป็นวิตามินบีชนิดหนึ่งที่ร่างกายต้องการ จะช่วยเสริมสร้างกระบวนการผลิตเซลล์ใหม่ให้มีสุขภาพดี
- ในผู้ที่ตั้งครรภ์ Folic Acid อาจช่วยป้องกันการแท้งบุตร ความพิการแต่กำเนิดเกี่ยวกับสมองและกระดูกสันหลังของทารก
- ช่วยป้องกันการกลายพันธุ์ของ DNA ซึ่งจะนำไปสู่การเป็นมะเร็งได้
- ใช้รักษาโรคโลหิตจางชนิดที่เกิดจากการขาดกรดโฟลิค ร่วมกับยารักษาตัวอื่น ๆ ด้วย
สัญญาณและอาการแสดงภาวะพร่องโฟเลต
- โรคโลหิตจางแบบเมกาโลบลาสติก เช่น เหนื่อยล้า อ่อนแรง
- หงุดหงิดฉุนเฉียว อารมณ์ตกต่ำ
- คลื่นไส้
- ปวดหัว
- ผมร่วง
- อาการนอนไม่หลับ
- ท้องร่วง
- เป็นแผลที่ลิ้นและเจ็บลิ้น
- การเปลี่ยนแปลงของเส้นผม ผิวหนัง และเล็บ
ปริมาณที่แนะนำต่อวัน
- Thai RDI : 200 ไมโครกรัม/วัน
- ภาวะขาดสารอาหาร : 1 ไมโครกรัม/วัน
- การดูแลก่อนการตั้งครรภ์ : 400-600 ไมโครกรัม/วัน
- ระหว่างตั้งครรภ์ : 600 ไมโครกรัม/วัน
- ระหว่างให้นมบุตร : 500 ไมโครกรัม/วัน
- สตรีที่เคยมีการคลอดบุตรภาวะ NTD : 5 ไมโครกรัม/วัน
แหล่งอาหารที่มีโฟเลต
- ผักใบเขียว : ผักขม 100 กรัม มีโฟเลตปริมาณ 225 ไมโครกรัม
- เมล็ดเขียว : เมล็ดถั่ว 100 กรัม มีโฟเลตปริมาณ 59 ไมโครกรัม
- ข้าวขาว : ข้าวขาวหุงสุก ครึ่งถ้วย มีโฟเลตปริมาณ 90 ไมโครกรัม
- ผักตระกูลถั่ว : ถั่วแดง 100 กรัม มีโฟเลตปริมาณ 394 ไมโครกรัม
อัตราค่าจัดส่ง
เราคิดค่าจัดส่งตามน้ำหนักสินค้าคะ ไม่มีขั้นต่ำของยอดซื้อ ลูกค้าซื้อสินค้าเพียง 1 ชิ้นเราก็บริการจัดส่งให้คะ

การบริบาลเภสัชกรรม



การบริบาลเภสัชกรรม หมายถึง ความรับผิดชอบของเภสัชกรที่มีต่อการใช้ยาของผู้ป่วย เพื่อให้ได้ผลการรักษาที่ถูกต้องและเพิ่มคุณภาพชีวิตผู้ป่วย
ร้านยาของเรา
| น้ำหนัก | 40 กรัม |
|---|